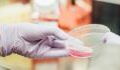
Coronavirus: Chinesische Labore können als Ursprung noch nicht ausgeschlossen werden

Drei Jahre nach dem Ausbruch der Corona-Pandemie sind sich Expert:innen immer noch weitgehend uneinig darüber, woher das Virus genau stammt. Während einige die Übertragung durch Fledermäuse als Ursache vermuten, gehen andere von einem Unfall in einem chinesischen Labor aus.
Eine brisante Äußerung eines CIA-Informanten sorgt diesbezüglich nun jedoch für Furore: Dieser hat nämlich vor dem Geheimdienstausschuss des US-Kongresses behauptet, die CIA habe Wissenschaftler:innen mit Geld bestochen, um ihre Aussagen bezüglich des Virus-Ursprungs zu beeinflussen.
Bestechung von CIA-Wissenschaftler:innen
Laut Angaben des deutschen Nachrichtenmagazins t-online sowie der New York Post und Fox News, geht es dabei um ein Gremium aus sieben Wissenschaftler:innen, die mit der Untersuchung des genauen Ursprungs des Virus beauftragt gewesen sind.
Sechs von ihnen sollen ursprünglich zu dem Schluss gelangt sein, dass das Coronavirus aus einem Labor im chinesischen Wuhan stammt. Die Behauptung lautet nun, dass diese sechs Wissenschaftler:innen von der CIA "finanzielle Anreize" bekommen haben sollen, damit sie ihre Meinung ändern und stattdessen eine Übertragung durch Tiere als Ursache angeben.
CIA weist Behauptungen zurück
Ob die Behauptungen des Informanten, mutmaßlich ein hochrangiger Beamter der CIA, der Wahrheit entsprechen, muss noch ermittelt werden - der Untersuchungsausschuss hat weitere Unterlagen von der CIA dazu angefordert. Der Informant selbst wird jedoch als "sehr glaubwürdige Quelle" angesehen.
Die CIA selbst hat diese Anschuldigungen umgehend zurückgewiesen und verweist in einer Pressemitteilung darauf, dass stets mit "analytischer Genauigkeit, Integrität und Objektivität" vorgegangen wird und man keine Wissenschaftler:innen dafür bezahle, ihre Meinung zu ändern.
Warum diese Ärztin BionTech auf 150.000 Euro verklagt hat, erfährst du in diesem Artikel.
Verwendete Quellen:
t-online: "Wurden Experten geschmiert? Coronavirus – CIA-Informant behauptet Brisantes"
New York Post: "CIA tried to pay off analysts to bury findings that COVID lab leak was likely: whistleblower"
Fox News: "Whistleblower alleges CIA offered officials money to change view of COVID origins"